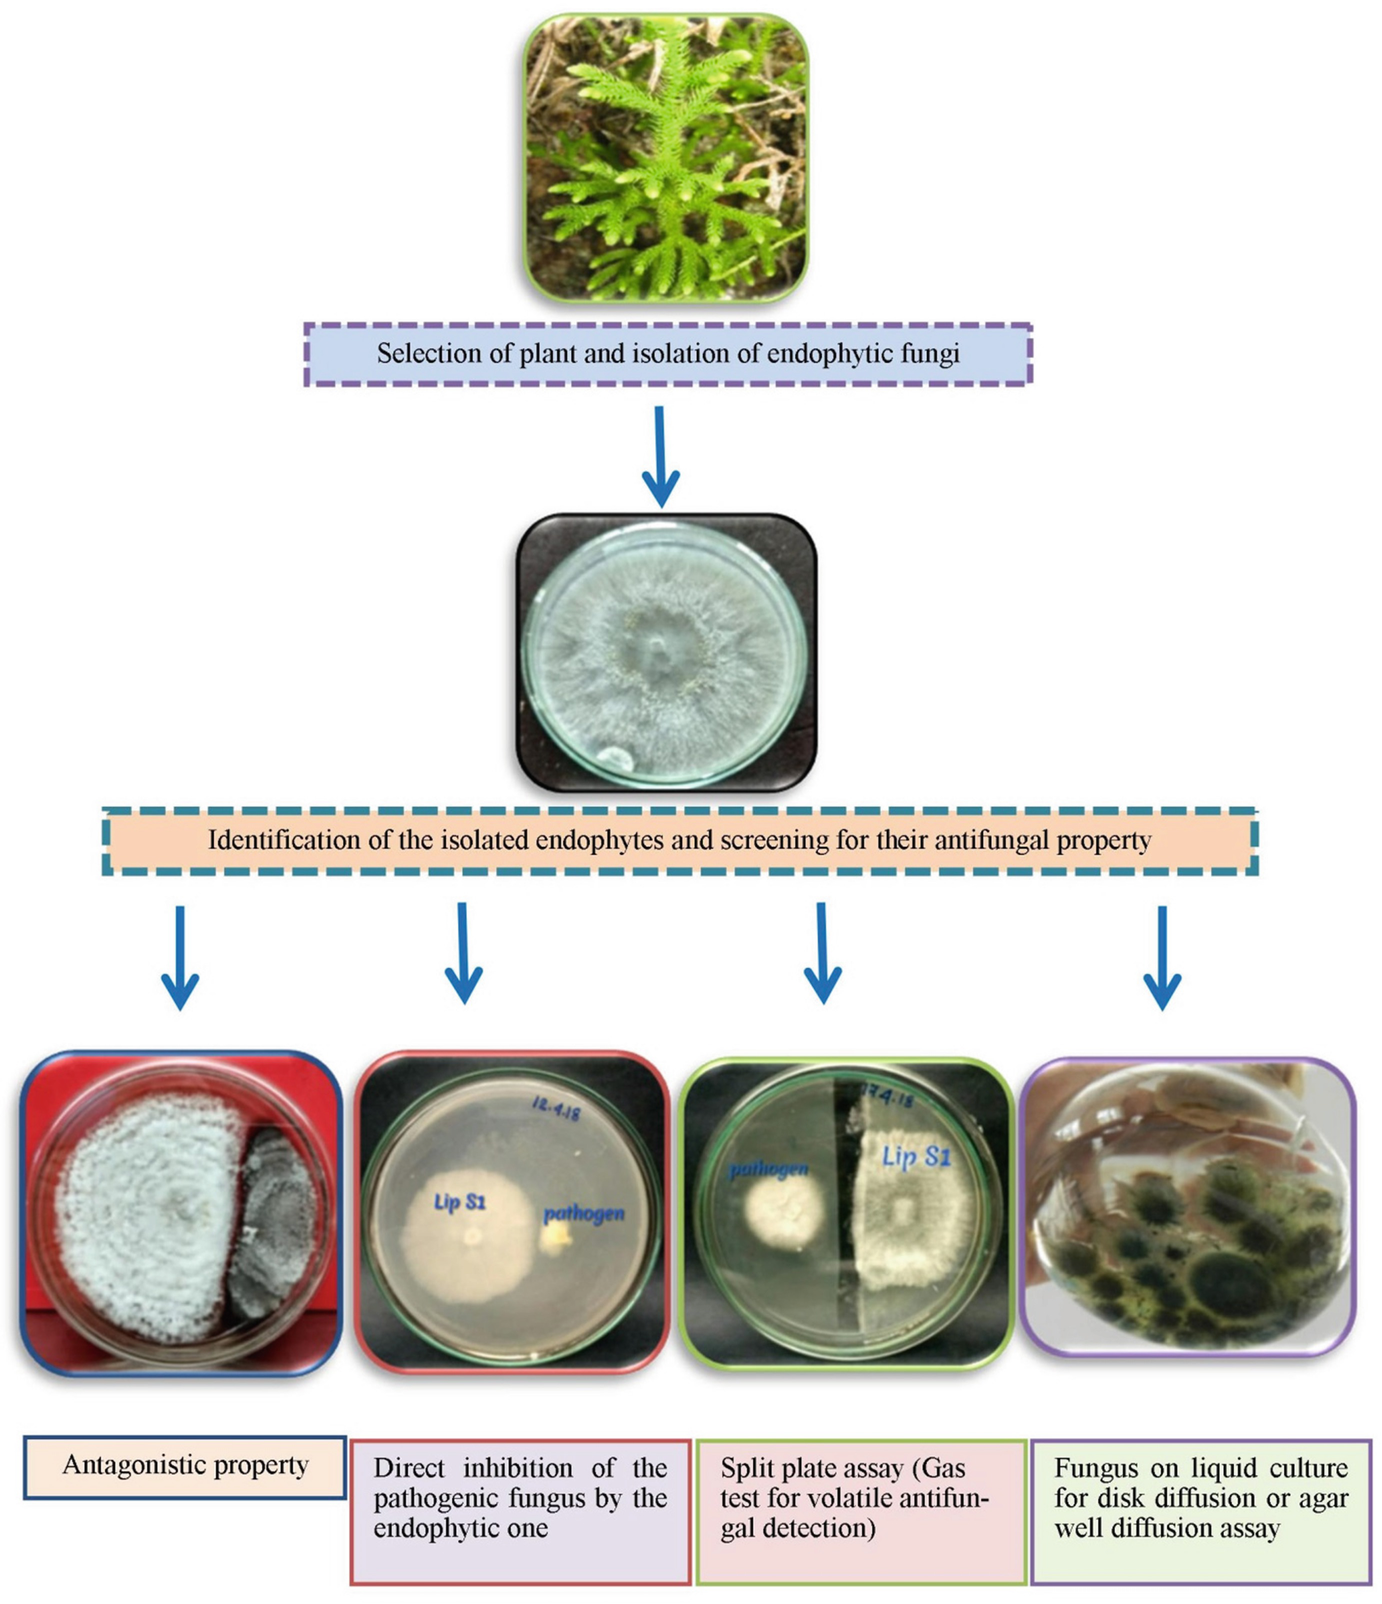

Garden Center Nj Organic Compounds Of Human Body
Garden Center Nj Organic Compounds Of Human Body, Indeed recently has been hunted by consumers around us, perhaps one of you personally. People now are accustomed to using the internet in gadgets to view video and image information for inspiration, and according to the name of this article I will discuss about
If the posting of this site is beneficial to our suport by spreading article posts of this site to social media marketing accounts which you have such as for example Facebook, Instagram and others or can also bookmark this blog page.

Eco Functionality Of Organic Matter In Soils Springerlink Garden Ideas Homemade All Organic Compounds Contain The Element
Common sources include land application and manufacturing centers of pesticides.
Garden ideas homemade all organic compounds contain the element. Rhababerone exists as a solid and is considered to be practically insoluble in water and relatively neutral. Zhunan jia hui zhang choon nam ong abhijeet patra yonghai lu chwee teck lim thirumalai venkatesan. A dual center study to compare breath volatile organic compounds from smokers and non smokers with and without copd.
Hundreds of volatile organic compounds vocs are released from human body fluids. 13s hpode also known as 13s hpode belongs to the class of organic compounds known as lineolic acids and derivatives. It serves as a fundamental course for understanding how organic compounds are assimilated into the body by digestion absorption and intermediary metabolism.
Allers m langejuergen j gaida a et al. Susceptibility of source water to community water supply wells in new jersey to contamination by volatile organic compounds. Treatment of vacutainers for the analysis of volatile organic compounds in human blood at the low parts per trillion level.
Hydroxyanthraquinones are compounds containing a hydroxyanthraquinone moiety which consists of an anthracene bearing a quinone and hydroxyl group. New jersey department of environmental protection. These are derivatives of lineolic acid.
Rhababerone also known as isoemodin belongs to the class of organic compounds known as hydroxyanthraquinones. Measurement of exhaled volatile organic compounds from patients with chronic obstructive pulmonary disease copd using closed gas loop gc ims and gc apci. Man made chemicals used to control pests weeds and fungus.
Accessed 10 july 2007. New jersey department of environmental protection source water assessment program. Volatile organic compounds vocs emitted by human body offer a unique insight into biochemical processes ongoing in healthy and diseased human organisms.
Prospects and challenges of volatile organic compound sensors in human healthcare. Examples include benzene methyl tertiary butyl ether mtbe and vinyl chloride. Unfortunately in many cases their origin and metabolic fate have not been yet elucidated in sufficient depth thus limiting their clinical application.
The primary goal of this work was to identify and quantify volatile organic compounds. Man made chemicals used as solvents degreasers and gasoline components. Acs sensors 2018 3 7 1246 1263.

Restoration Of Soil Quality Using Biochar And Brown Coal Waste A Review Sciencedirect Garden Ideas Homemade All Organic Compounds Contain The Element





